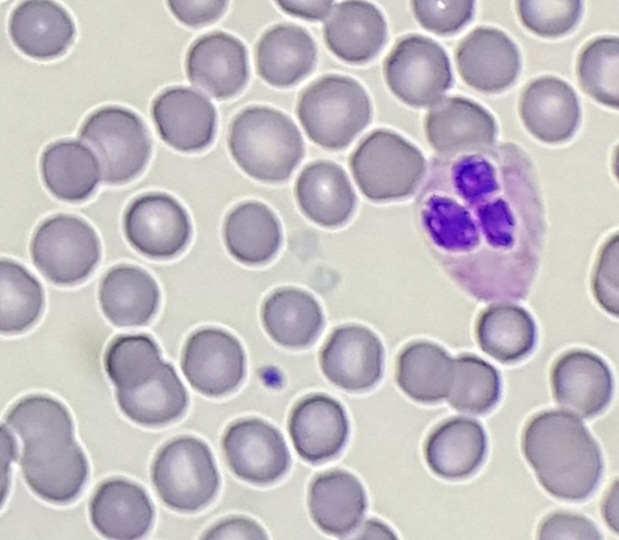
gray-platelet-small

Platelet clumping can cause a falsely lowered platelet count on hematology instruments and can be difficult to resolve. With thrombocytopenia, physicians need an accurate count to diagnose, treat, or monitor patients. Clumping can be due to pre-analytic issues with specimen handling, can be caused by medications, or may be an in vitro phenomenon caused by anticoagulants. The clumping makes precise counting impossible and even estimates can be very tricky. If there are clumps, and recollection of the sample still yields platelet clumping, then many labs will have an alternate tube drawn or an alternative method to help resolve clumping.
Many of us have heard of using sodium citrate tubes for patients who have clumped platelets in EDTA. So, if you are having platelet clumping headaches, you can just order some sodium citrate tubes and start using those on your hematology analyzers, right? Not so fast. There are many published references of the use of sodium citrate tubes to resolve EDTA induced thrombocytopenia but we still see samples in which the clumping is not resolved with the sodium citrate tube. Published studies have shown that several other alternate methods have been helpful in resolving platelet clumping issues. These include drawing specimens in CTAD, ACD, or ‘ThromboExact’1 tubes, or adding amikacin or kanamycin to the EDTA after the specimen is drawn.
So, why can’t we just order one of these other tubes and start reporting results? Hematology analyzers are only FDA approved for EDTA tubes. Before you can use any modified method, and before you can report any patient results, your laboratory must do validation or verification studies to prove that the method produces valid results.
A validation provides objective evidence that a test performs as intended. A validation uses a defined process and is used when setting up and implementing a new test. One example is a laboratory developed test (LDT), which is a test performed by the clinical laboratory in which the test was developed. A LDT can be one that is neither FDA-cleared nor FDA-approved or can be one that is FDA cleared/approved but has been modified by the performing laboratory. The use of sample types or the use of collection devices not listed in manufacturer instructions constitute modifications, by this definition. In a validation, accuracy should be tested with at least 40 samples across the analytical measurement range (AMR). Correlations are then performed. Precision should be tested over approximately 20 days. A verification, on the other hand, uses an abbreviated process and is used when setting up and implementing new tests that are cleared or approved by FDA. Before reporting patient results, the laboratory must demonstrate that a test performs in agreement with prior claims and must demonstrate performance specifications are comparable to the manufacturer’s specifications. Verification therefore is a confirmation that a test method meets specified requirements and would be applied to a method which has already been validated. For a verification, a smaller sample size may be used, and precisions tested over 5 or more days.

So, which would you do if you wanted to use an alternate method for reporting platelet counts? Hematology analyzers are only FDA approved for platelet counts on EDTA, but the by which the sample is analyzed does not change with an alternate tube, so it may be possible to do a limited validation or verification with a smaller sample size. A laboratory needs to prove correlation, accuracy, and precision. Follow your laboratory SOPs for validation/verification and consult with your accrediting agencies, if necessary. A plan needs to be written and signed off by laboratory director. Choose the alternative method you wish to investigate and run correlations for platelet counts on EDTA and the alternate anticoagulant. If your instrument has more than one platelet mode, it is important to run samples in the mode which you would normally use for thrombocytopenia or flagged platelet counts. Apply any dilutional factors and calculate correlations. This data will be Included in your report, which, along with a procedure needs to be signed by the laboratory director.
The most important thing is to write a plan and a follow-up report according to your SOPs and to make sure any requirements of accrediting agencies are included. There can be some differences in interpretation of standards, so it is the laboratory’s responsibility to make sure what you have done meets the standards that apply to your lab.
The use of alternate tubes for platelet counts has been well reviewed in literature. Sodium citrate tubes are the most common, likely because they are the easiest to use and the most cost effective. Remember though that sodium citrate and other methods cannot resolve all case s of pseudothrombocytopenia. There are several special notes to consider. Counts from sodium citrate tubes are known to be stable for approximately 3 hours, after which counts decrease. As well, it has been shown in literature that sodium citrate tubes do show a negative bias. It has been reported that the 10% dilutional factor may be too low. Some studies have been done to determine dilution factors that correlate more closely with EDTA tubes, and researchers have suggested factor of 17%-25%. If your laboratory wishes to determine its own dilutional factor for sodium citrate or other tubes, this will also have to be included in your platelet studies. Lastly, CBCs are calibrated for EDTA, so only the platelet count should be reported from an alternative anticoagulant.
The end of another busy and challenging year is upon us, and at this time of year we can find ourselves rushed to finish ‘end of year’ tasks such as competencies and continuing education requirements. and a response to Sysmex’s recent webinar “Those Sticky, Tricky Platelets – Solving the Puzzle of Platelet Clumping” (Oct.20,2021). After the webinar I had many questions from techs asking, “Do we need to validate our alternative method?” and “How do we go about doing that?” The webinar discusses pseudothrombocytopenia and its causes in more detail than my earlier blog from Oct 2019, “Hematology Case Study: The Story of the Platelet Clump: EDTA-Induced Thrombocytopenia”. The webinar can be found at https://webinars.sysmex.com/webinars/11ae743e-ac99-47e7-acb7-2b24cedc1a1a and is available for CEU, free of charge.
References
- Baccini V, Geneviève F, Jacqmin H, et al. Platelet Counting: Ugly Traps and Good Advice. Proposals from the French-Speaking Cellular Hematology Group (GFHC). J Clin Med. 2020;9(3):808. Published 2020 Mar 16. doi:10.3390/jcm9030808
- Bizzaro N. (2013): Pseudothrombocytopenia. In: Platelets, Vol. 3, ed Bizzaro N, Elsevier, Amsterdam, pp. 989–997
- Chae H, Kim M, Lim J, Oh EJ, Kim Y, Han K: Novel method to dissociate platelet clumps in EDTA-dependent pseudothrombocytopenia based on the pathophysiological mechanism. Clin Chem Lab Med 50, 1387–1391 (2012)
- Socha, Becky. Calibration and Calibration Verification: Who, What, Where, When, Why, How & Did I Pass or Fail?. AMT 81st Educational Program and annual meeting, 2019
- Zhou X, Wu X, Deng W, Li J, Luo W: Amikacin can be added to blood to reduce the fall in platelet count. Am J Clin Pathol 136, 646–652 (2011)
- https://www.cms.gov/Regulations-and-Guidance/Legislation/CLIA/downloads/6065bk.pdf
- https://www.cap.org/laboratory-improvement/proficiency-testing/calibration-verification-linearity
- https://www.westgard.com/cal-verification-criteria.htm
- https://labmedicineblog.com/2019/10/29/ hematology-case-study-the-story-of-the-platelet- clump-edta-induced-thrombocytopenia/

-Becky Socha, MS, MLS(ASCP)CMBBCM graduated from Merrimack College in N. Andover, Massachusetts with a BS in Medical Technology and completed her MS in Clinical Laboratory Sciences at the University of Massachusetts, Lowell. She has worked as a Medical Technologist for over 40 years and has taught as an adjunct faculty member at Merrimack College, UMass Lowell and Stevenson University for over 20 years. She has worked in all areas of the clinical laboratory, but has a special interest in Hematology and Blood Banking. She currently works at Mercy Medical Center in Baltimore, Md. When she’s not busy being a mad scientist, she can be found outside riding her bicycle.